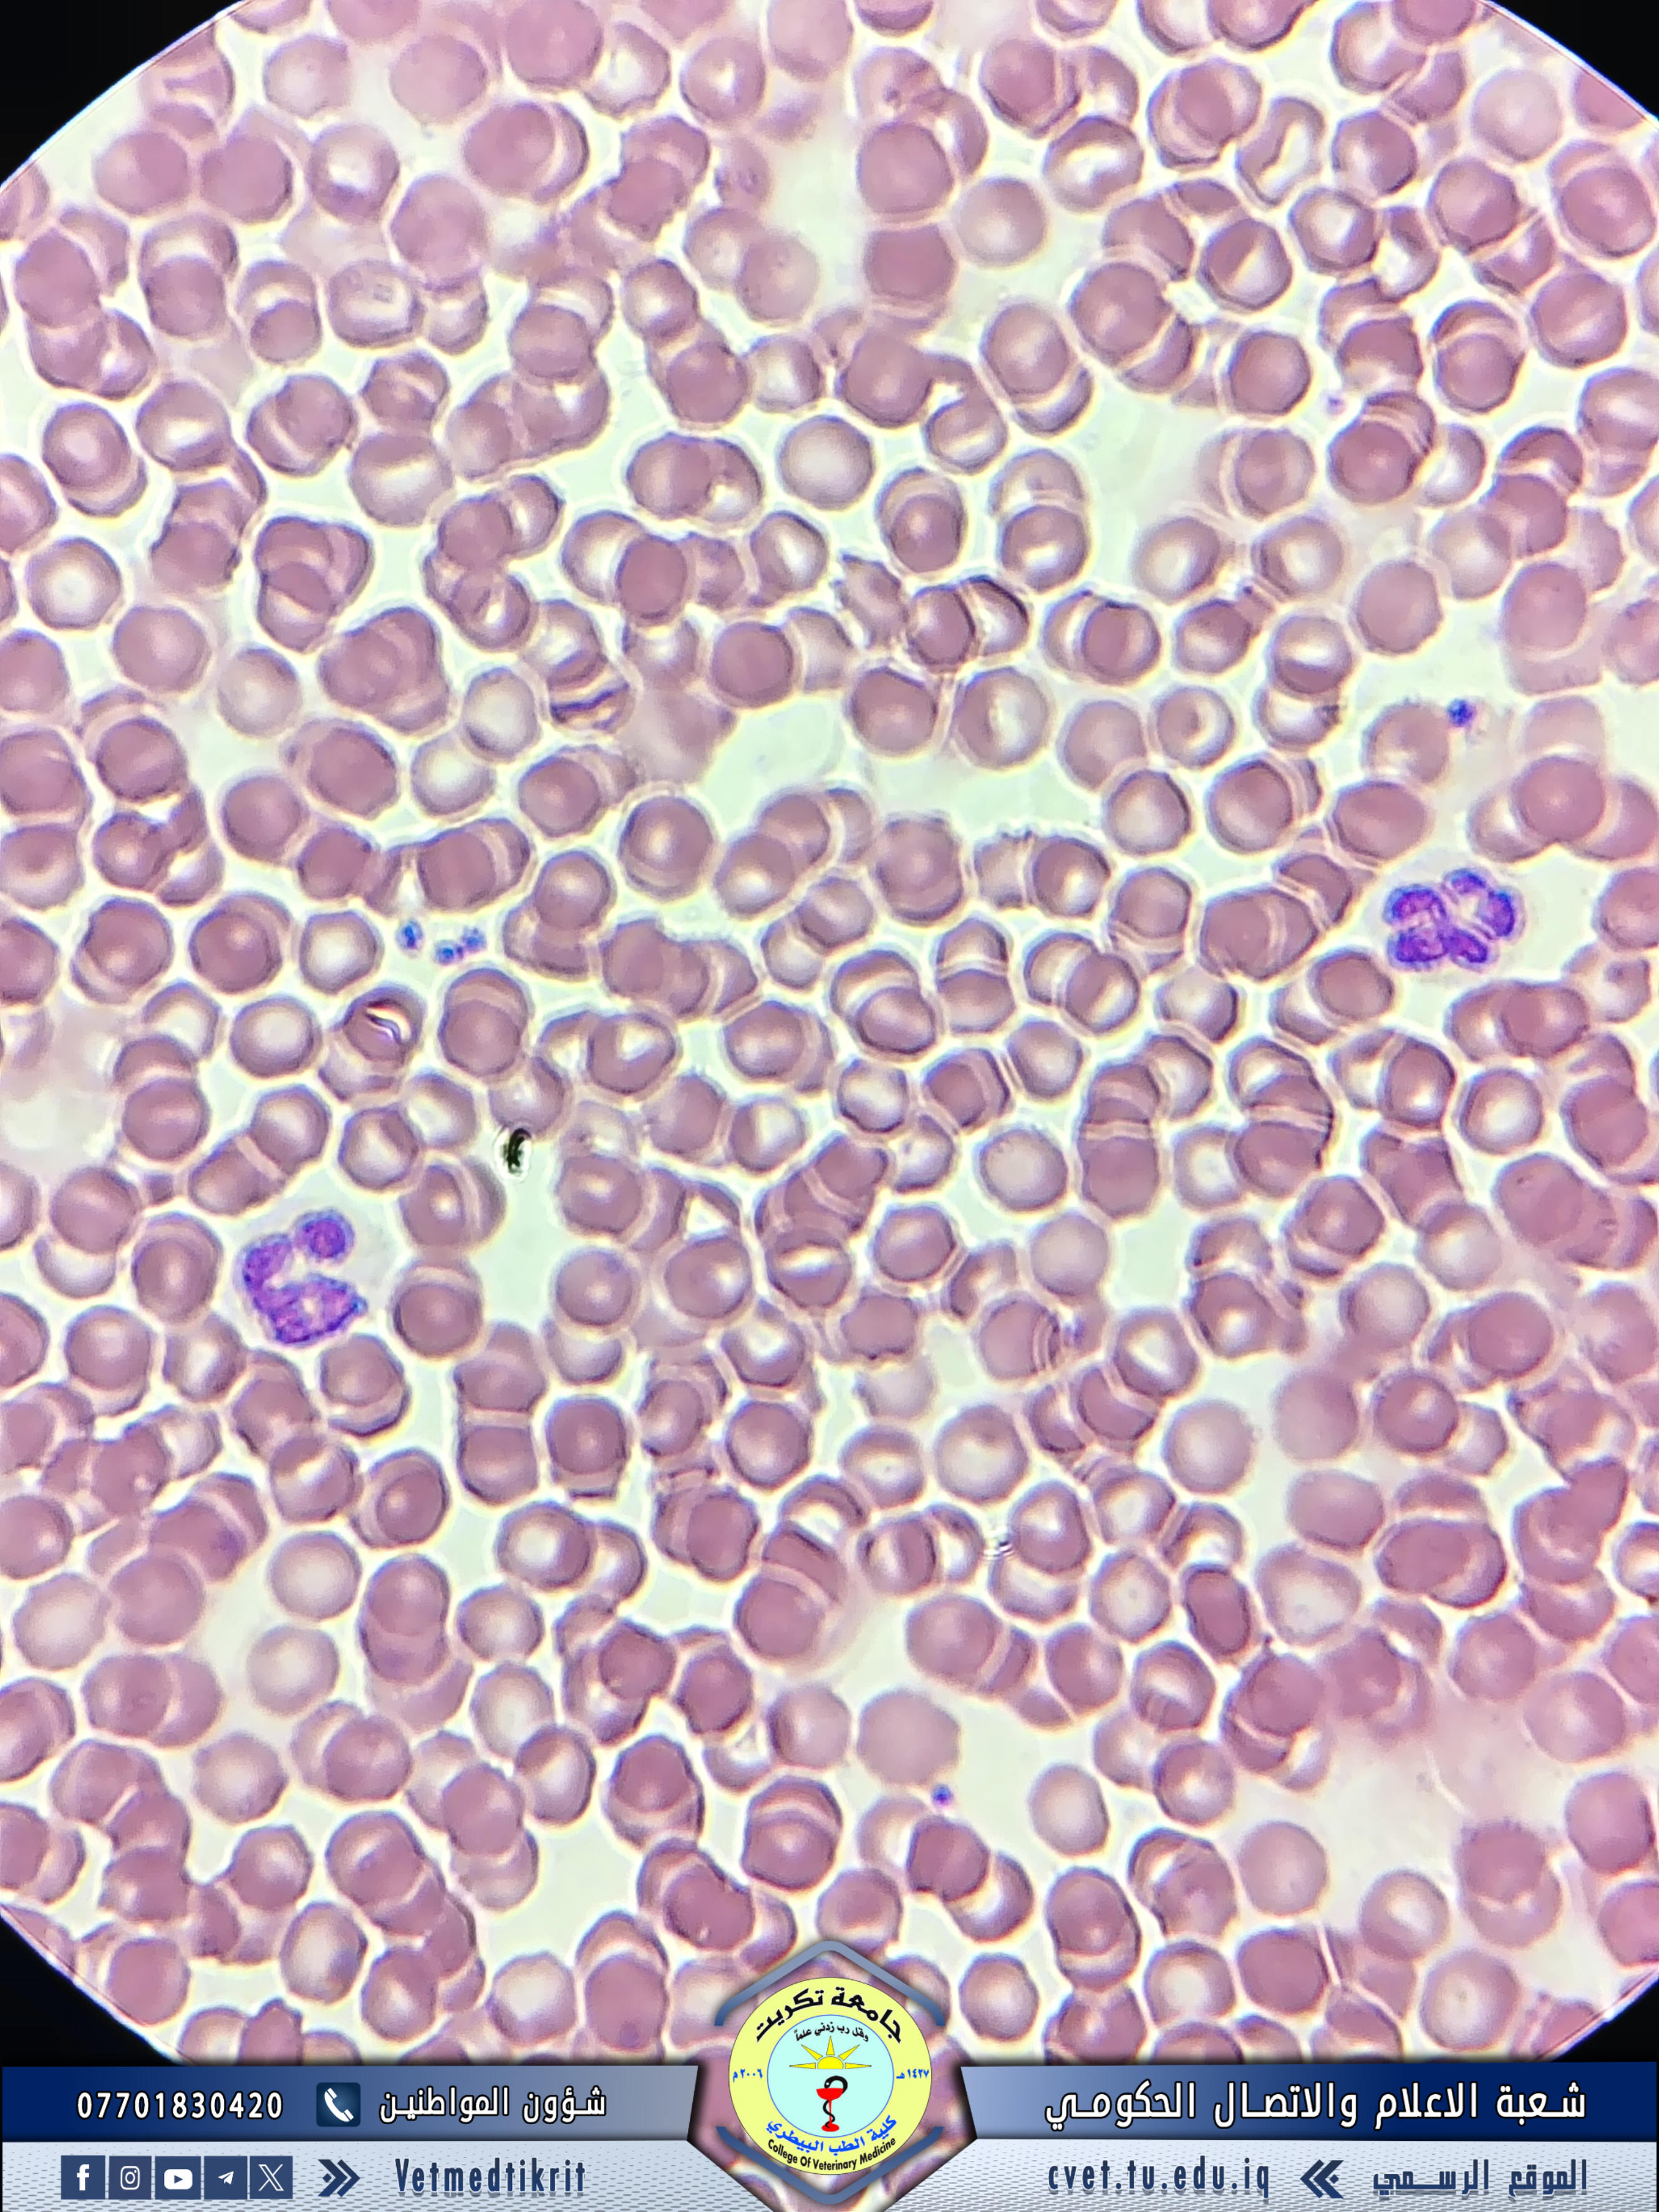

ضمن نشاطات خدمة المجتمع التي تقدمها كلية الطب البيطري بجامعة تكريت للقوات الامنية، استقبلت وحدة العيادة الخارجية التابعة للكلية حالة كلب بوليسي يعاني من ضعف عام، وهزال، وانقطاع في الشهية، مع ارتفاع في درجة حرارة الجسم. قام الفريق الطبي المكون من د. علي غازي عطية، ود. ماهر صابر عوين، وم.م. منار صباح عيسى، والطبيب البيطري موسى دخيل بحر، بفحص الحالة وإجراء فحص مجهري لعينة الدم المسحوبة. أظهرت نتائج الفحص وجود التهاب حاد وتغيرات في الصورة الدموية، وتم وضع خطة علاجية متكاملة للحيوان، شملت تقديم الرعاية الطبية المناسبة لتحسين حالته الصحية. تؤكد وحدة العيادات الخارجية استقبالها كافة الحالات البيطرية مجاناً، حرصاً على تقديم الخدمات البيطرية للمجتمع وتحسين صحة الحيوانات.
عنوان الجامعة
تكريت ، صلاح الدين
بريد الكتروني 42
الرمز البريدي 34001
العراق